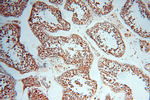
AK2 Antibody in Immunohistochemistry (Paraffin) (IHC (P))
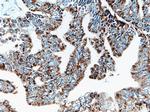
AK2 Antibody in Immunohistochemistry (Paraffin) (IHC (P))

Search
Proteintech
AK2 Polyclonal Antibody
{{$productOrderCtrl.translations['antibody.pdp.commerceCard.promotion.promotions']}}
{{$productOrderCtrl.translations['antibody.pdp.commerceCard.promotion.viewpromo']}}
{{$productOrderCtrl.translations['antibody.pdp.commerceCard.promotion.promocode']}}: {{promo.promoCode}} {{promo.promoTitle}} {{promo.promoDescription}}. {{$productOrderCtrl.translations['antibody.pdp.commerceCard.promotion.learnmore']}}
产品信息
11014-1-AP
种属反应
已发表种属
宿主/亚型
分类
类型
抗原
偶联物
形式
浓度
规格
纯化类型
保存液
内含物
保存条件
运输条件
产品详细信息
Immunogen sequence: MAPSVPAAE PEYPKGIRAV LLGPPGAGKG TQAPRLAENF CVCHLATGDM LRAMVASGSE LGKKLKATMD AGKLVSDEMV VELIEKNLET PLCKNGFLLD GFPRTVRQAE MLDDLMEKRK EKLDSVIEFS IPDSLLIRRI TGRLIHPKSG RSYHEEFNPP KEPMKDDITG EPLIRRSDDN EKALKIRLQA YHTQTTPLIE YYR (1-202 aa encoded by BC009405)
靶标信息
Adenylate kinases are involved in regulating the adenine nucleotide composition within a cell by catalyzing the reversible transfer of phosphate groups among adenine nucleotides. Three isozymes of adenylate kinase, namely 1, 2, and 3, have been identified in vertebrates; this gene encodes isozyme 2. Expression of these isozymes is tissue-specific and developmentally regulated. Isozyme 2 is localized in the mitochondrial intermembrane space and may play a role in apoptosis. Two transcript variants encoding distinct isoforms have been identified for this gene.
仅用于科研。不用于诊断过程。未经明确授权不得转售。
生物信息学
蛋白别名: Adenylate kinase 2, mitochondrial; adenylate kinase 2, mitochondrial {ECO:0000255|HAMAP-Rule:MF_03168}; adenylate kinase isoenzyme 2, mitochondrial; Adenylate monophosphate kinase; adenylate monophosphate kinase {ECO:0000255|HAMAP-Rule:MF_03168}; AK 2; AK 2 {ECO:0000255|HAMAP-Rule:MF_03168}; ATP-AMP transphosphorylase 2; ATP-AMP transphosphorylase 2 {ECO:0000255|HAMAP-Rule:MF_03168}; ATP:AMP phosphotransferase; ATP:AMP phosphotransferase {ECO:0000255|HAMAP-Rule:MF_03168}; testis secretory sperm-binding protein Li 220n; unnamed protein product
基因别名: ADK2; Ak-2; AK2; D4Ertd220e
UniProt ID: (Human) P54819, (Rat) P29410, (Mouse) Q9WTP6
Entrez Gene ID: (Human) 204, (Rat) 24184, (Mouse) 11637